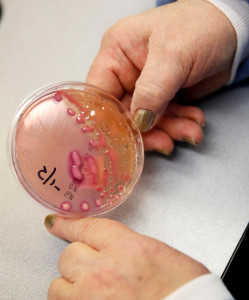

Health
More News
-
What is it like to be a travel blogger during a pandemic?
Two young women share their insights on the topic
-
No DRAP nod for Covid-19 vaccine trials
Clinical trials will be conducted under DRAP supervision soon after approval of vaccines
-
New WHO guidance calls for more evidence on airborne transmission
Only a very small number of diseases are believed to be spread via tiny floating particles or aerosols, WHO says
-
'Strong evidence' mothers can transmit virus to newborns
The number of women that could be affected by this could be potentially very high, says WHO
-
Sindh edges close to 100,000 Covid-19 cases
23 more deaths, 1,736 fresh cases reported in province
-
NCOC says 77 coronavirus patients died in last 24 hours
Currently, there are 94,713 active Covid-19 cases in the country
-
Brazil's Bolsonaro tests positive for coronavirus
Brazilian president had earlier claimed Covid-19 as a 'little flu'
-
Beijing reports zero virus cases for first time since new outbreak
The Beijing government has tested more than 11 million people for Covid-19 since June 11
-
WHO to travellers: keep an eye on 'anywhere and everywhere' Covid-19
This virus is widespread and people have to take that very, very seriously, says WHO spokesperson
-
UAE says it will test 2 million people for Covid-19 as cases rise
The regional business and tourism hub on June 24 removed a nationwide curfew in place since mid-March
-
Deepika Padukone to join virtual session on mental wellness in Covid-19 era
Padukone will talk about dealing with the stress, anxiety and depression during the pandemic
-
WHO says reviewing NYT article on concerns over airborne spread of Covid-19
The WHO says the Covid-19 disease spreads primarily through small droplets
-
Israel reimposes series of restrictions after coronavirus spike
Scenes of Israelis ignoring social distancing restrictions and orders to wear masks outside have been common
-
Mainland China reports eight new coronavirus cases, two in Beijing
98% of the total cases were mild and normal
-
Spain imposes second local coronavirus lockdown in two days
Only those who need to travel for work will be allowed to leave or enter the area.
-
Nine small changes that make a happier home
From good smells to simple de-cluttering, here are nine ways you can elevate your space
-
Authorities pay tribute to health professionals
Govt officials, civil society mark 100 days of national resolve in fighting the pandemic
-
Businesses running with smart lockdowns in place: Umar
Minister praises health workers’ role in fighting virus during visits to isolation centre, NIH
-
Sindh to see increase in oxygenated beds
Govt decides to convert over 8,000 beds at isolation facilities into HDU beds, procure ventilators
-
Sindh lifts ban on inter-district transport
The restriction on public transport travelling between provinces remains in place
-
Demystifying allergies: more than coughs and sneezes
Here's how to best manage allergies
-
Due to Covid-19: Routine vaccinations drop across Sindh
Citizens fear contracting the virus, visit EPI centres less often, says health minister
-
DHOs told to shape up or pack up
Officials drop the ball on virus tests, pandemic policies
-
Other deaths spike in Indian city ravaged by coronavirus
Spike in deaths in Ahmedabad as patients not able to go to hospitals due to virus fears, say doctors
-
‘Global pneumonia guidelines need revision’
Study by AKU researchers highlights risk of unnecessary antibiotic use
-
Can cooking reduce your blood pressure?
Latest study seems to suggest so…
-
Sindh sees highest single-day percentage of Covid-19 positive cases
The number of infected persons has increased to 84,656 and death toll climbed to 1,377 so far in the province
-
DHQ Ziarat, Sanjavi get new ambulances
DHQ Ziarat, Sanjavi get new ambulances
-
Pandemic 'is not even close to being over', WHO chief says
Although many countries have made some progress globally, the pandemic is actually speeding up
-
Dispelling misconceptions: A mango is healthier than you think
Health expert says the fruit is among the best sources of essential vitamins and minerals in summer
-
PM Imran lauds team for being first to enforce 'smart lockdowns'
He says Pakistan must follow SOPs in order for the country to successfully combat Covid-19
-
Telemedicine project to begin in Lahore
Minister issues orders for setting up patient helpline
-
‘Routine immunisation must continue’
To save children from different diseases says Punjab Health Minister
-
LIVE: Pakistan's death toll surpasses 4,000 as Covid-19 cases soar to 197,705
Nationwide coronavirus tally to rise to almost 225,000 by month-end, says Asad Umar
-
Has Covid-19 made health budgets respectable?
As far as the health expenditure is concerned, the pandemic never happened
-
Even as Sindh boosts capacity, fewer get tested for Covid-19
Social stigma surrounding coronavirus leaves people wary of diagnosis, say health dept officials
-
Over 3,000 Covid-19 patients critically ill in Pakistan
Daily fatalities more than double to hit 148, new cases rise after 5-day decline
-
Smart lockdown expanded to posh areas in Lahore
Minister says govt following WHO advice on pandemic
-
'Rs90 set aside for a single citizen in health budget'
YDA accuses Balochistan govt of neglecting health sector
-
Pakistan's coronavirus cases fall for fifth consecutive day
Nationwide Covid-19 tally surpasses 190,000 mark as daily figures plunge and single-day fatalities down too
-
Beijing officials declare new coronavirus outbreak 'under control'
Official says the prevention and control situation remains complicated, we cannot lower our guard in the slightest
-
LIVE: New coronavirus cases continue to surface across country, taking tally to 191,088
NDMA distributes ninth batch of safety equipment to Balochistan, K-P
-
K-P to promote specialist doctors
Doctors serving in management cadre will also be promoted
-
After Covid-19, Typhoid rears head in K-P
Testing facilities claim disease is spreading faster than expected
-
LIVE: Smart lockdown aimed at isolating maximum cases, says Umar as tally hits 187,443
Covid-19 has claimed at least 3,732 lives while around 73,471 patients have recovered
-
OPDs to reopen in Sindh govt hospitals as GHA calls off strike
Development comes after the provincial government accepts demands
-
In pictures: China's Covid-19 testing lab with air-inflated structure goes into operation
Beijing recently confirmed a new cluster of coronavirus cases in the city
-
Sindh health dept seeks ‘curfew’ in Karachi
Provincial health authorities recommend stricter lockdown in 182 of Karachi’s 247 UCs
-
LIVE: Pakistan's Covid-19 tally soars to 179,634 as Sindh sees surge in infections
Pakistan to reopen Ghulam Khan border terminal for trade with Afghanistan from Monday
-
China sees European virus strain in Beijing, WHO says more study needed
China released genome sequencing data from samples taken in Beijing, identified as European strain
1594367782-0/FotoJet-(5)1594367782-0-405x300.webp)